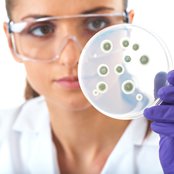

Nursing jobs are in demand, which is one reason why nursing is such a great career choice. Salary also is generally very good at all levels of nursing…and you don’t have to worry you’ll be stereotyped. You’ll find there’s a wide variety of specializations and practice areas within the nursing profession. Do you like working with children? Explore your opportunities as a pediatric nurse. Rather work with seniors? Becoming a geriatric nurse may fulfill those career ambitions. Perhaps you want to become a surgical nurse and work alongside surgeons…or a nurse anesthetist who helps administer anesthesia to patients. Nurses also might choose to specialize in OB/GYN, oncology, medical/surgical, or any number of specialty areas. The possibilities are virtually limitless. Because some specialties, such as anesthetist, oncology, and surgical/intensive care nursing, require specialized knowledge, they often pay more. And those with nursing degrees often qualify for other opportunities, including as home care providers and travel nurses. In many cases, travel nurses can be assigned to various cities across the country and work in hospitals, clinics, or facilities for several months at a time. If you’re looking for a little adventure in life, that could be an option worth considering. Check out www.fortis.edu to see what other doors nursing might open for you…and then start making a difference! Dr. Anders is a Fellow of the Academy of Nursing Education and elected to the American Academy of Nursing.